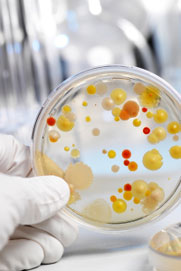

Splošne informacije
Kaj je Sanosil?
Sanosil je patentirana formula, edinstvena zmes vodikovega peroksida in srebra. Idealna je za dezinfekcijo površin in èišèenje vode.
Je Sanosil ostrega vonja, kot na primer belilo?Ne. Sanosil nima vonja.
Je Sanosil okolju prijazen?
Da. Sestavine v Sanosilu se razkrojijo v vodo in kisik in ne onesnažujejo okolja s stranskimi produkti.
Ali je Sanosil registriran v Sloveniji?
Da. Register biocidnih proizvodov RS pod številko Št.: 18415-158, 18415-159, 18415-160, 5406-108.
Ali Agencija za varstvo okolja (EPA) Sanosil odobrava?Da. Sanosil je vpisan v register EPA pod številko 84526-1, kot sredstvo za dezinfekcijo površin in èišèenje vode.
Dezinfekcijsko razpršilo Sanosil
za površine
Kaj pomeni »dezinfekcija brez dotika«?
Brisanje površin mikrobe raznaša naokoli, z ene površine na drugo. Ker Sanosil ni strupen, splakovanje ali brisanje ni potrebno.Enostavno razpršite in pojdite.
Kako uèinkovit je Sanosil v primerjavi z drugimi dezinfekcijskimi sredstvi?
Visoka uèinkovitost
Sanosil je dezinfekcijsko sredstvo širokega spektra, ki unièi raznolike bakterije, viruse ali plesni. Je enako, èe ne še bolj uèinkovit, kot druga dezinfekcijska sredstva.
Izboljšana varnost
Belila in druga sredstva za dezinfekcijo so kancerogena (povzroèajo raka) in mutagena (povzroèajo mutiranje genov). Poleg tega dražijo oèi, kožo in otežujejo dihanje.
Ali Sanosil unièi virus H1N1 (nova gripa)?
Da. Sanosil je bil neodvisno testiran in potrjen za unièevanje virusa nove gripe (H1N1). Uèinkovit je tudi proti mutiranim virusom, saj proti mikroorganizmom deluje na tri naèine. Druga vodilna dezinfekcijska sredstva proti mikroorganizmom delujejo le na en naèin, zato pa niso uèinkovita proti mutiranim virusom.
Proti katerim organizmom na površinah je Sanosil še uèinkovit?
- nova gripa (oblika H1N1)
- virus bolezni New Castle
- virus Herpes
- antraks
- legionela
- listerija
- meningitis
- ptièja gripa (oblika H5N1)
- E. coli
- gripa A (oblika Hong Kong VR-544)
- gripa A (oblike HSNI, HS, H7 in H9
- bakterija MRSA
- norovirus
- rinovirus (prehlad)
- virus HIV
- salmonela
- psevdomonas
- Enterobacter aerogenes
- Trihofiton
- bakterije, ki reducirajo sulfat (angl. SRB)
- veè kot 140 drugih mikroorganizmov
Ali je Sanosil uèinkovit proti plesni?
Da. Sanosil je uèinkovit proti razliènim tipom plesni, vkljuèno proti plesnim Aspergilus niger in Trihofiton mentagrofit.
Ali Sanosil uèinkuje dlje in zašèiti dezinfecirano površino?
Da. Sanosil za seboj na podlagi pusti neškodljiv in neopazen sloj srebrovih ionov. To prepreèuje ponovno kontaminacijo.
Kje lahko uporabljamo Sanosil?
- doma
- dnevna oskrba
- bolnišnice
- hoteli
- telovadnice
- najrazliènejša prevozna sredstva: letala, vlaki, taksiji
- veterinarske ordinacije
- èakalnice
- pisarne
Na katerih površinah lahko uporabljamo Sanosil?
- stranišèa, odlagalne površine, pomivalna korita
- kljuke
- igraèe
- športna oprema
- zdravstvena oprema
- tekaèi (v telovadnicah)
- savna
- pohištvo
- revije
- itd.
Dezinfekcijsko sredstvo Sanosil Vodni Mikrobiocid
za vodo
Je Sanosil jedek oz. koroziven?
Ne. Sanosil je v primerjavi s klorom, bromom in kvartarnimi amonijevimi kationi znatno manj koroziven oz. jedek. Poleg tega Sanosil ne pušèa solnih oblog v vodnih sistemih.
Ali Sanosil ohranja isto raven pH in temperaturo?
Da. Sanosil je uèinkovit pri razliènih pH vrednostih ter pri temperaturah vode v razponu med 0°C in 95°C.
Proti katerim organizmom v vodi je Sanosil uèinkovit?
- biofilm oz biološka prerast
- legionela
- salmonela
- E. coli
- bakterije, ki reducirajo sulfat (angl. SRB)
- bakterije, ki tvorijo filamente
- mikrobiološko izzvana korozija (angl. MIC)
- psevdomonas
- veèina drugih grampozitivnih in gramnegativnih bakterij
Ali se Sanosil splaèa oz. ali je stroškovno uèinkovit?
Da. Povpreèno za dezinfekcijo potrebujemo desetkrat manjšo kolièino Sanosila kot belila ali broma, s èimer privarèujemo kar 30 % neto.
Ali je za doziranje Sanosila potrebno imeti drago opremo?
Ne. Sanosil enostavno in hitro vkljuèimo v sistem, poleg tega pa ne potrebujemo nobene zahtevne in drage opreme.